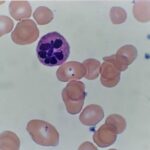
Hematology Case Studies-Megaloblastic Anemia
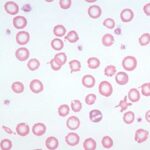
Normal RBC Mild hypochromia
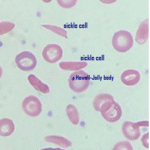
Sickled rbc with howell-jolly body
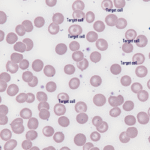
Hematology Case Studies-Target cells and microcytes
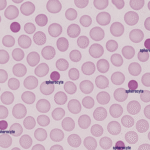
Spherocytes
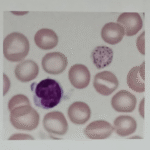
BASOPHILIC STIPPLINGS

Hematology Case Studies
ASCP Hematology Case Studies for ASCP Exam Prep:
Hematology is the study of blood, blood-forming organs, and blood diseases. In a clinical setting, the ability to interpret hematologic findings and correlate them with real patient scenarios is essential for accurate diagnosis and effective treatment.
These hematology case studies are designed to bridge the gap between textbook knowledge and real-world practice. Each case highlights common—and sometimes rare—hematologic conditions through a patient-centered narrative. From interpreting CBC values to analyzing peripheral blood smears and bone marrow reports, these cases challenge you to think critically, just as you would in the laboratory or on the ASCP exam.
Let’s begin exploring real hematology cases—where every drop of blood tells a story.
Anemias :
Case Study 1: Iron Deficiency Anemia
A 29-year-old female presents with progressive fatigue and paleness. She reports heavy menstrual periods and follows a vegetarian diet. Physical examination reveals pale conjunctiva and a heart rate of 102 bpm.
CBC and iron studies:
- Hemoglobin: 9.0 g/dL
- Hematocrit: 28%
- MCV: 71 fL
- Serum Iron: 30 µg/dL
- TIBC: 460 µg/dL
- Ferritin: 9 ng/mL
- RDW: Elevated
Which of the following is the most likely diagnosis based on the laboratory data and clinical history?
A. Thalassemia trait
B. Anemia of chronic disease
C. Iron deficiency anemia
D. Sideroblastic anemia

Answer: C. Iron deficiency anemia
The patient exhibits a classic microcytic, hypochromic anemia (low MCV and hemoglobin), and the low ferritin level confirms iron deficiency. Elevated TIBC and low serum iron support this. The history of heavy menses and vegetarian diet further reinforces iron loss and poor intake.
- Thalassemia trait often has normal RDW and normal ferritin
- Anemia of chronic disease shows low serum iron but normal to high ferritin
- Sideroblastic anemia typically presents with ringed sideroblasts in bone marrow and increased serum iron
Case Study 2: Megaloblastic Anemia Due to Vitamin B12 Deficiency
A 56-year-old vegan woman presents with fatigue, glossitis, and numbness in her feet. CBC reveals the following:
- Hemoglobin: 8.4 g/dL
- MCV: 116 fL
- WBC: 3.4 x10⁹/L
- Platelets: 120 x10⁹/L
- Peripheral smear: Macro-ovalocytes and hypersegmented neutrophils
- Serum B12: Low
What is the most likely underlying cause of this patient’s anemia?
A. Iron deficiency
B. Folate deficiency
C. Vitamin B12 deficiency
D. Myelodysplastic syndrome
Answer: C. Vitamin B12 deficiency
The presence of macrocytic anemia with neurologic symptoms (numbness) and hypersegmented neutrophils is strongly suggestive of vitamin B12 deficiency. A low serum B12 confirms this. Folate deficiency also causes macrocytosis but lacks neurologic findings.
Case Study 3: Anemia of Chronic Disease in a Diabetic Patient
A 68-year-old male with type 2 diabetes and chronic kidney disease presents with low energy. CBC and iron studies:
- Hemoglobin: 10.2 g/dL
- MCV: 88 fL
- Ferritin: 200 ng/mL
- Serum Iron: 30 µg/dL
- TIBC: 180 µg/dL
What is the most likely type of anemia in this patient?
A. Iron deficiency anemia
B. Sideroblastic anemia
C. Anemia of chronic disease
D. Thalassemia minor
Answer: C. Anemia of chronic disease
This patient has normocytic anemia with low serum iron but elevated ferritin (an acute-phase reactant), typical in chronic diseases such as CKD. Unlike iron deficiency, ferritin levels are not decreased
Case Study 4: Sickle Cell Crisis in a Teenager
A 16-year-old African American male presents to the ER with severe bone pain, fever, and dehydration. History reveals sickle cell disease. Labs:
- Hemoglobin: 7.8 g/dL
- MCV: 85 fL
- Reticulocyte count: Elevated
- Peripheral smear: Sickle-shaped cells and target cells
Which of the following best explains this patient’s elevated reticulocyte count?
A. Bone marrow failure
B. Increased red cell destruction
C. Aplastic crisis
D. Vitamin B12 deficiency
Answer: B. Increased red cell destruction
Sickle cells have a shortened lifespan (~20 days), leading to constant hemolysis and compensatory reticulocytosis. An aplastic crisis would show a low reticulocyte count, not elevated.
Case Study 5: Thalassemia Trait Misdiagnosed as Iron Deficiency
A 24-year-old Asian woman is found to have low hemoglobin during a pre-employment screening. She is asymptomatic.
- Hemoglobin: 10.5 g/dL
- MCV: 68 fL
- Serum Iron: Normal
- Ferritin: Normal
- RBC count: Elevated
- Hb electrophoresis: Increased HbA2
What is the most likely diagnosis?
A. Iron deficiency anemia
B. Thalassemia trait
C. Megaloblastic anemia
D. Sideroblastic anemia
Answer: B. Thalassemia trait
Microcytosis with normal iron studies and an elevated RBC count point to thalassemia minor. The key finding is elevated HbA2 on electrophoresis, distinguishing it from IDA, which usually has low RBC count and ferritin.
Case Study 6: G6PD Deficiency and Hemolytic Anemia
A 23-year-old male of Mediterranean descent presents with dark urine and fatigue 2 days after taking sulfa antibiotics.
CBC and smear:
- Hemoglobin: 8.9 g/dL
- MCV: 88 fL
- Reticulocyte count: ↑
- Total bilirubin: ↑
- Peripheral smear: Bite cells and Heinz bodies
- G6PD: Low
What is the most likely mechanism of this patient’s anemia?
A. Immune-mediated hemolysis
B. Oxidative damage to red blood cells
C. Vitamin B12 deficiency
D. Bone marrow failure

Answer: B. Oxidative damage to red blood cells
G6PD protects RBCs from oxidative injury. Sulfa drugs trigger hemolysis in G6PD-deficient patients, leading to bite cells and Heinz bodies. This is a non-immune intravascular hemolysis
Case Study 7: Aplastic Anemia After Viral Illness
A 16-year-old male presents with bruising, fatigue, and infections. He recently had a severe viral illness.
CBC:
- Hemoglobin: 6.5 g/dL
- WBC: 1.2 x10⁹/L
- Platelets: 15 x10⁹/L
- Reticulocyte count: ↓
- Bone marrow biopsy: Hypocellular with fatty replacement
Which of the following best describes this patient’s condition?
A. Hemolytic anemia
B. Aplastic anemia
C. Acute leukemia
D. Myelofibrosis

Answer: B. Aplastic anemia
Pancytopenia with hypocellular marrow is diagnostic for aplastic anemia. Viral illnesses, especially parvovirus B19 or hepatitis viruses, can trigger it.
Case Study 8: Autoimmune Hemolytic Anemia with Positive DAT
A 35-year-old woman presents with fatigue, jaundice, and dark urine. She has a history of lupus.
CBC and tests:
- Hemoglobin: 7.8 g/dL
- MCV: 90 fL
- Reticulocyte count: ↑
- LDH: ↑
- Bilirubin: ↑
- Direct Antiglobulin Test (DAT): Positive (IgG)
What is the most likely diagnosis?
A. Sickle cell anemia
B. G6PD deficiency
C. Warm autoimmune hemolytic anemia
D. Iron deficiency anemia
Answer: C. Warm autoimmune hemolytic anemia
Positive DAT (Coombs test) with spherocytes and anemia points to warm AIHA, often associated with autoimmune diseases like lupus. Hemolysis is extravascular and immune-mediated.
Case Study 9: Lead Poisoning-Induced Anemia
A 5-year-old boy presents with fatigue, abdominal pain, and developmental delay. He lives in an old house with peeling paint.
CBC and smear:
- Hemoglobin: 8.5 g/dL
- MCV: 72 fL
- Peripheral smear: Basophilic stippling
- Serum lead level: Elevated
Which peripheral smear finding is characteristic of this condition?
A. Target cells
B. Howell-Jolly bodies
C. Heinz bodies
D. Basophilic stippling
Answer: D. Basophilic stippling
Lead interferes with heme synthesis, leading to microcytic anemia and basophilic stippling. It’s common in children exposed to lead paint or contaminated water.

Case Study 10: Acute Blood Loss Anemia From Trauma
A 32-year-old male is brought to the ER after a motorcycle accident. He is pale and hypotensive.
Labs after 24 hours:
- Hemoglobin: 8.1 g/dL
- Hematocrit: 24%
- MCV: 90 fL
- Reticulocyte count: ↑↑
What does the increased reticulocyte count indicate in this scenario?
A. Bone marrow failure
B. Chronic anemia
C. Active bone marrow compensation
D. Vitamin B12 deficiency

Correct Answer: C. Active bone marrow compensation
In acute blood loss, the bone marrow responds by increasing reticulocyte production to replace lost RBCs. A high reticulocyte count indicates a healthy marrow response.
RESOURCES:
- Rodak’s Hematology: Clinical Principles and Applications, 6th Edition
- ASCP BOC Study Guide, 6th Edition
- Mayo Clinic: Iron Deficiency Anemia Diagnosis
.
- ASCP BOC Study Guide
- Clinical Hematology Atlas
- Medscape – Thalassemia
